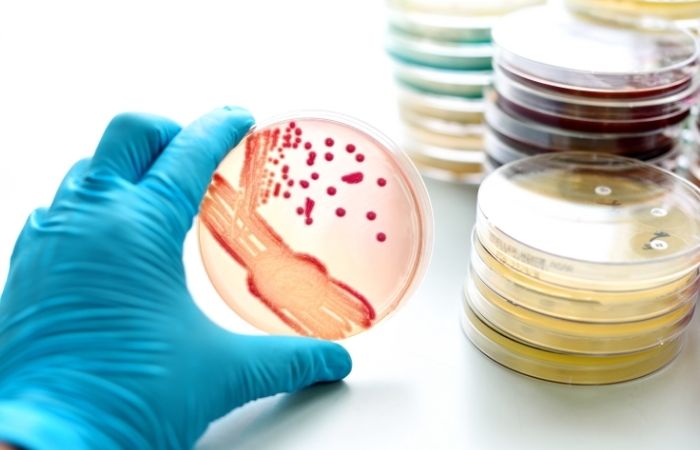

The Year Superbugs Went Mainstream
“We’re staring down a post-antibiotic era for some STIs, full stop.”
That blunt warning from a CDC briefing set the tone this spring. Case counts tell the same story: the ECDC logged a 31 % jump in gonorrhoea and a 75-year high in syphilis across Europe. Meanwhile, Canadian labs report 19 % dual-class resistance in M. genitalium. Against that backdrop, dating-app downloads hit record highs, showing how quickly biology and behavior can collide. The legacy of 2025 will hinge on how fast we replace myths with evidence-based action.
People are also looking for: What does an oral syphilis sore look like?
Myth #1: “Antibiotic Resistance Is Rare, It Won’t Happen to Me”
The numbers say otherwise. In Bangkok tourist clinics, one in eight gonorrhoea samples now carries decreased susceptibility to the last-line drug ceftriaxone. A 2024 Lancet Infectious Diseases editorial warns that global resistance could make standard therapy obsolete within a decade.
“Resistance isn’t a glitch in the matrix, it is the matrix,” quips Dr. Saira Patel, a London sexual-health consultant. Translation: rare is rapidly becoming routine, especially if testing lags behind travel.
Myth #2: “One Pill of Azithromycin Still Cures Everything”
Azithromycin once crushed chlamydia and gonorrhoea in a single dose. Today, macrolide resistance approaches 95 % in Treponema pallidum (syphilis) and 60 % in M. genitalium. Even chlamydia cure rates have dipped below 90 %. The WHO GASP network now discourages azithro monotherapy for gonorrhoea anywhere on Earth. Still reaching for that leftover Z-Pak? You may kill only the weak bacteria and leave super-resistant survivors partying unchecked.
Myth #3: “If Symptoms Disappear, You’re Cured”
Gonorrhoea symptoms often fade as the immune system turns down inflammation, even while bacteria persist. In one 2024 JAC study, 38 % of patients who self-reported “feeling fine” after treatment still tested positive on culture. Left unchecked, residual infection can scar fallopian tubes, inflame the prostate, and seed resistant genes into sexual networks. Only a repeat test-of-cure proves eradication, and that’s where at-home swabs shine: discreet, fast, and lab-verified.
Check Your STD Status in Minutes
Test at Home with RemediumGonorrhea Test Kit

Order Now $33.99 $49.00
Myth #4: “Doxy-PEP Will Replace Condoms, Problem Solved”
Doxycycline post-exposure prophylaxis (Doxy-PEP) can slash bacterial-STI risk by up to 66 % in high-frequency users, according to a 2023 NEJM trial. But bacteria evolve. Modeling studies predict widespread doxy use could accelerate tetracycline resistance within three years. The CDC’s 2024 guidance labels Doxy-PEP “promising but provisional,” recommending it only for specific groups and always alongside quarterly testing. Condoms still block every resistant clone, no prescription required.
Myth #5: “At-Home Kits Can’t Detect Drug-Resistant STIs”
True, that little cassette you pee on in your bathroom can’t tell which antibiotic will work, yet. But many modern mail-in kits forward positive samples to partner labs that run reflex culture or PCR-based resistance panels. A Canadian pilot published this year in CMAJ Open found dual-class resistance in M. genitalium was identified just as reliably from self-collected swabs as from clinic-collected ones. “If the sample is good, the science is agnostic to where it was taken,” notes Dr. Rowan Blake, lead author. Translation: DIY doesn’t mean DIYagnostics.
The trick is choosing a kit that:
- Includes throat, rectal, and genital swabs
- Promises laboratory reflex testing for any positives
- Offers follow-up telehealth with susceptibility-guided prescriptions
Skip those specs and you’re basically mailing your future to a magic-8 ball.

People are also looking for: Can chlamydia be treated without antibiotics?
Reality Check: The 2025 Testing Playbook
So, what does an evidence-based test plan look like? Think of it as the “three-site, three-step” model:
- Screen broadly with NAATs at throat, rectum, and genital sites every 1–3 months if you have new partners.
- Confirm positives with culture-based or molecular AST when available.
- Test-of-cure 7–14 days post-therapy to ensure antibiotics actually worked.
Point-of-care AST devices are inching closer to mainstream. A 2024 prototype profiled in Nature Reviews Microbiology delivered ceftriaxone susceptibility results in under five hours, fast enough for same-visit prescribing. Until tech like that hits every clinic, your safest bet is rigorous follow-up.
Pregnancy, Fertility, and the Price of Ignoring Resistance
Drug-resistant STIs aren’t just a singles-scene headache. Congenital syphilis cases in the U.S. jumped 10-fold since 2012, with macrolide-proof strains creeping into prenatal clinics. Untreated resistant gonorrhoea can cause pelvic inflammatory disease, raising infertility risk by up to 20 percent. The CDC now urges expectant parents to test in both first and third trimesters, plus anytime there’s a new partner.
“We can’t let fear of stigma cost someone their future family,” says Dr. Leila Ortiz, obstetric-infectious disease specialist. Her clinic pairs every positive prenatal screen with an automatic partner notification and mail-in resistance assay, closing the loop before labor begins.
The Bottom Line: Resistance Loves Complacency, Not Complexity
Antibiotic-resistant STIs flourish when we oversimplify. Myths sell a single story; microbes write sequels. By layering screening sites, confirming cures, and demanding susceptibility data, you make life complicated, for the pathogen. And complicated bugs struggle to spread.
FAQs
1. Are drug-resistant STIs more contagious than regular ones?
No, the transmission route is identical. The danger is that failed treatment keeps you contagious longer, widening the infection window.
2. How can I tell if I have a drug-resistant infection?
You can’t by symptoms alone. Ask for a culture or molecular antimicrobial-susceptibility test (AST) after any positive NAAT result, per CDC guidance.
3. Do condoms still protect against super-gonorrhoea?
Yes. Barriers block bacteria regardless of their resistance profile, a simple, effective safeguard endorsed by the WHO.
4. Will a standard at-home STI panel detect resistance?
Most show only presence of the bug. Choose kits that forward positives for lab-based AST or sequencing for a full resistance picture.
5. Is antibiotic resistance permanent in my body?
No. Once the infection is cleared with an effective drug, resistant bacteria leave with it. But you can be reinfected by another resistant strain.
6. Should I stop antibiotics early if symptoms vanish?
Never. Cutting therapy short selects for the toughest bacteria and fuels resistance, warns the ECDC.
7. Does taking Doxy-PEP create more resistance?
Possibly over time. Current CDC advice restricts it to high-risk groups and pairs its use with quarterly testing to monitor resistance trends.
8. Are pregnant people at higher risk from resistant STIs?
Yes, untreated infections can cross the placenta, causing miscarriage or congenital disease. Prenatal guidelines call for repeat testing and AST-guided therapy.
9. Can natural remedies cure antibiotic-resistant STIs?
No herbal, probiotic, or DIY concoction has clinical proof of curing STIs. Stick to evidence-based medicine and verified test-of-cure results.
10. How soon should I retest after treatment?
Get a test-of-cure 7–14 days post-therapy for gonorrhoea or M. genitalium; 3 months later for chlamydia and syphilis, even if you feel fine.
Keep Curiosity, Kill Complacency
Myths thrive in silence; resistance thrives on myths. Break the feedback loop by asking one extra question, “Which antibiotic still works?”, every time you test or treat. Swab widely, verify cures, and treat with data, not guesswork. In a world where bacteria evolve faster than social trends, your curiosity is the most potent antimicrobial on the shelf.
Sources
1. Centers for Disease Control and Prevention – Drug-Resistant Gonorrhoea
2. European Centre for Disease Prevention and Control – Gonorrhoea





